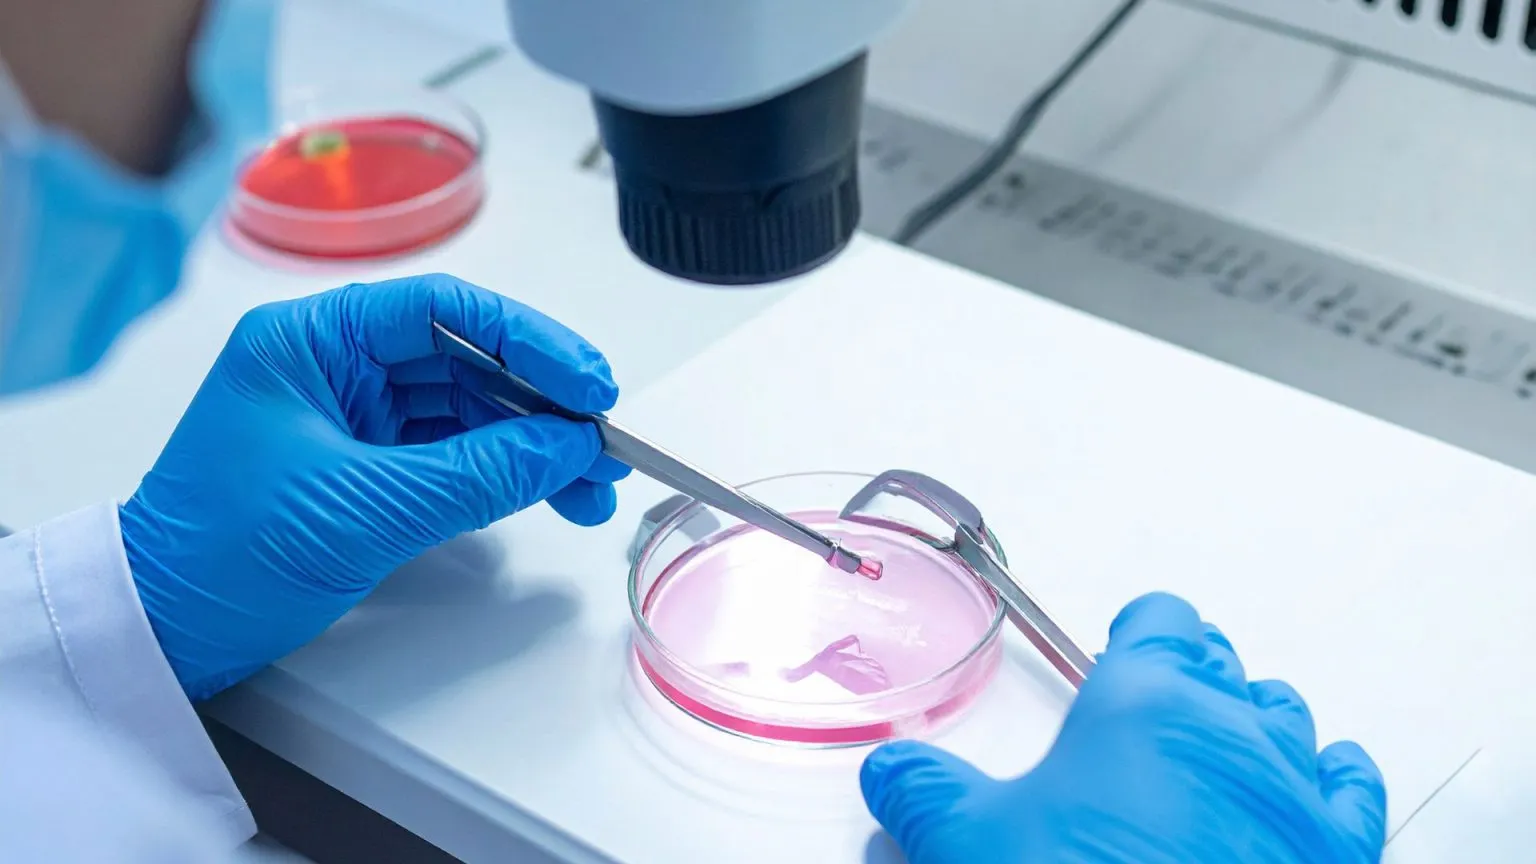

From clinic registration to staff hiring, permissions, and ART Act compliance — we help you run your fertility center smoothly and legally.

MedGuide is a dedicated guiding consultancy platform designed to support healthcare professionals, embryologists, clinicians, and entrepreneurs in establishing and managing state-of-the-art IVF laboratories, ART Level 1 & Level 2 clinics, and ART Banks in compliance with the ART (Regulation) Act, 2021 and the Surrogacy (Regulation) Act, 2021.
With expertise in reproductive medicine regulations, clinical workflow planning, quality assurance systems, and documentation. MedGuide offers clear, step-by-step guidance for every stage of setup and compliance—so you can focus on delivering safe and ethical reproductive care.
At MedGuide, we assist with:






Running an IVF or Surrogacy clinic requires precise compliance, proper staffing and continuous documentation, which can feel overwhelming. We simplify the entire process so your clinic operates smoothly and confidently.

We decode the confusing ART & Surrogacy regulations for you.

We provide straightforward steps for every approval and documentation.

Get help from experts who understand IVF setup, staffing & permissions.

So you can focus on patient care while we handle compliance.

Setup, staffing, compliance, permissions — everything in one place.

We prepare complete, compliant paperwork to avoid delays or rejections.
Their clear guidance and structured process made compliance effortless for our clinic. Every approval was handled smoothly and on time.

We provide complete compliance, setup, permission assistance, and staffing support for IVF, ART & Surrogacy clinics across India.
© 2026. All Rights Reserved. Designed and Developed by Invoidea Technologies
We provide complete compliance, setup, permission assistance, and staffing support for IVF, ART & Surrogacy clinics across India.
© 2025. All Rights Reserved. Designed and Developed by Invoidea Technologies
WhatsApp us